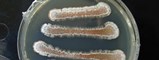
Cropped100201Slividans

New 'Genome Mining' Technique Streamlines Discovery From Nature
Method allows scientists to match compounds produced in the wild back to their genomic origins
Scripps Institution of Oceanography / University of California, San Diego
A newly developed method for microscopically extracting, or "mining," information from genomes could represent a significant boost in the search for new therapeutic drugs and improve science's understanding of basic functions such as how cells communicate with one another.
Analyzing marine and terrestrial samples obtained from Alaska to San Diego's La Jolla Cove, a research technique jointly created by scientists at Scripps Institution of Oceanography and Skaggs School of Pharmacy and Pharmaceutical Sciences at UC San Diego and their colleagues taps powerful laboratory instruments to trace promising chemical compounds back to their genomic roots. The method is described in the October 9 online publication of the journal Nature Chemical Biology.
Graduate student Roland Kersten developed a technique that employs mass spectrometry, a mass analyzing tool that deciphers the size and makeup of molecules, to reveal core structural details of genomes.
"With only very small amounts of crude sample material, the mass spectrometer is able to fragment the unknown peptide into individual amino acid building blocks, so we can then map those to the genome level," said Kersten, who works jointly in Pieter Dorrestein's laboratory at the School of Pharmacy and Brad Moore's lab at the Scripps Center for Marine Biotechnology and Biomedicine. "That provides us information about how to reassemble the molecule."
Knowing such minutiae through this genomic "mining" approach gives scientists a way to connect the natural chemicals produced by organisms back to the enzymes that construct them. These "biosynthetic pathways" are considered prized information in the search for new pharmaceuticals to treat diseases.
Using the new method, the scientists have already discovered two new classes of peptides, compounds made of amino acids that serve in functions ranging from communication to protection.
"This represents a paradigm shift in the way that natural products are discovered and characterized, and it's fundamentally different than what's been practiced for the past decades in this field," said Moore, a professor at Scripps and the Skaggs School of Pharmacy and Pharmaceutical Sciences at UC San Diego. "This has the capability of really changing the way natural products, or simply chemicals, are discovered in nature."
Dorrestein, Moore and Kersten are working on ways to automate the process to more quickly analyze biological samples. They believe the new technique will streamline the discovery of promising natural products.
"We're trying to bring up the speed of discovery in chemistry," said Moore. "There's a huge amount of information that's out there and we are only scratching the surface-we'd like to dig a little deeper."
"My UC San Diego colleague Bill Gerwick often states that natural products are a part of central dogma following DNA, RNA and proteins" said Dorrestein. "I agree with Bill, natural products and related chemistries control biology yet these molecules are difficult to characterize. The tools for characterizing the molecules that control biology have not kept pace with modern science. The thought process introduced in this manuscript provides the foundation for finally bringing the fourth branch of central dogma into the realm of modern life sciences."
In addition to Kersten, Moore and Dorrestein, coauthors of the paper include Yu-Liang Yang and Yuquan Xu of the Skaggs School; Peter Cimermancic and Michael Fischbach of UC San Francisco; and Sang-Jip Nam and William Fenical of Scripps Oceanography.
The National Institutes of Health and the Beckman Foundation provided financial support for the research.
About Scripps Institution of Oceanography
Scripps Institution of Oceanography at University of California, San Diego, is one of the oldest, largest and most important centers for global science research and education in the world. Now in its second century of discovery, the scientific scope of the institution has grown to include biological, physical, chemical, geological, geophysical and atmospheric studies of the earth as a system. Hundreds of research programs covering a wide range of scientific areas are under way today in 65 countries. The institution has a staff of about 1,400, and annual expenditures of approximately $170M from federal, state and private sources. Scripps operates robotic networks, and one of the largest U.S. academic fleets with four oceanographic research ships and one research platform for worldwide exploration. Birch Aquarium at Scripps serves as the interpretive center of the institution and showcases Scripps research and a diverse array of marine life through exhibits and programming for more than 415,000 visitors each year. For more information, visit scripps.ucsd.edu.
SOURCE: Scripps Institution of Oceanography